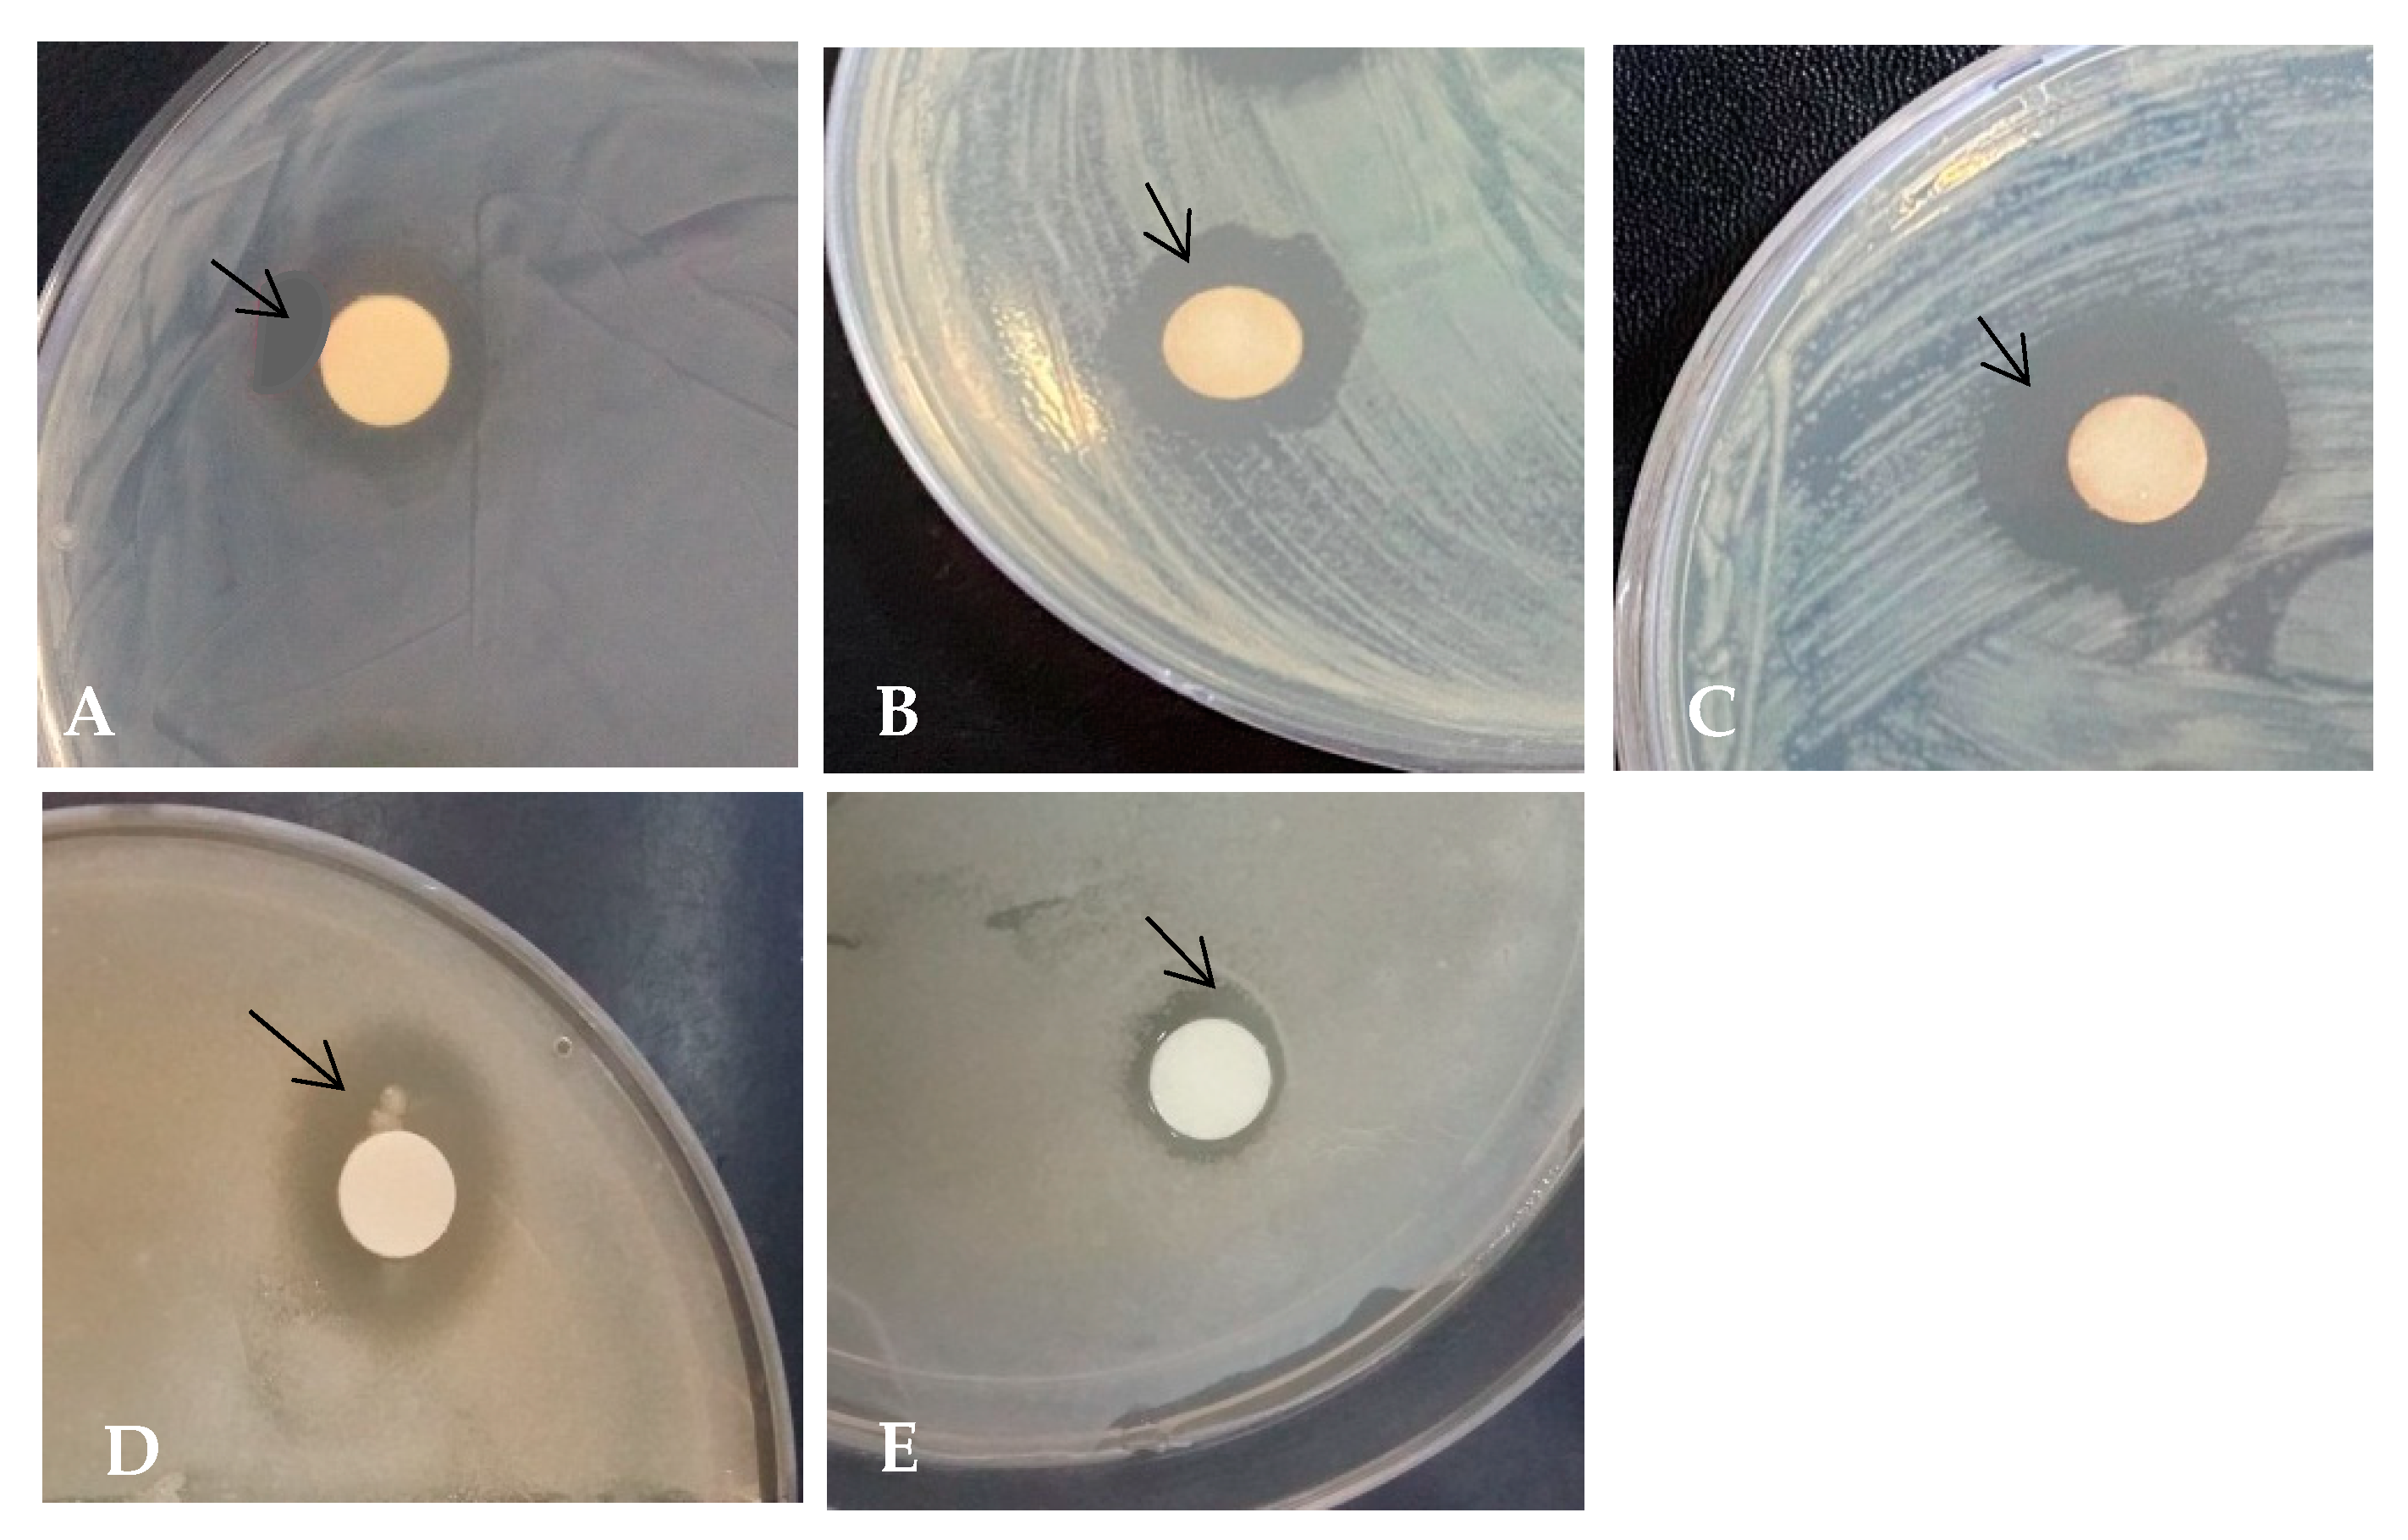
Agronomy 11 00305 g007

The Influence of Light Wavelength on Resveratrol Content and Antioxidant Capacity in Arachis hypogaeas L.
Abstract
:1. Introduction
2. Materials and Methods
2.1. Chemicals
2.2. Plant Growth Conditions and Treatment
2.3. Preparation of Extracts
2.3.1. Total Phenolic Content
2.3.2. Total Flavonoid Content
2.4. Effect of Light Quality on Antioxidant Activity
2.4.1. DPPH Method
2.4.2. ABTS Assay
2.5. Tyrosinase Inhibition Assay
2.6. Liquid Chromatography/Tandem Mass Spectrometry (LC/MS) Analysis of Resveratrol
2.7. Determination of Cytotoxicity
2.7.1. Cell Culture
2.7.2. MTT Assay
2.7.3. Qualitative Observation of Live and Dead Cell Staining Using Fluorescent Microscope
Preparation of the Cells
Microscopic Documentation of Dead and Live Cells
2.8. Antimicrobial Activity
2.8.1. Disc Diffusion Method
2.8.2. LIVE/DEAD BacLight Bacterial Viability Test
2.9. Statistical Analysis
3. Results
3.1. The Total Phenolic Content and Total Flavonoid Content of Peanut Sprout Grown under Different LED Types
3.2. Resveratrol Content in Peanut Sprout Extracts Grown under Different LED Types
3.3. Variation in the Antioxidant Properties of Peanut Sprouts Grown under Different LED Types
3.4. Tyrosinase Activity in Peanut Sprouts Grown under Different LED Types
3.5. Cytotoxic Effect (MTT Assay)
3.6. Antimicrobial Activity of Peanut Sprouts Measured Using the Zone of Inhibition Assay
4. Discussion
5. Conclusions
Supplementary Materials
Author Contributions
Funding
Institutional Review Board Statement
Informed Consent Statement
Data Availability Statement
Conflicts of Interest
References
- Freitas, F.O.; Moretzsohn, M.C.; Valls, J.F.M. Genetic variability of Brazilian Indian landraces of Arachis hypogaea. L. Genet. Mol. Res. 2007, 6, 675–684. [Google Scholar]
- Zhao, X.; Chen, J.; Du, F. Potential use of peanut by-products in food processing: A review. J. Food Sci. Technol. 2012, 49, 521–529. [Google Scholar] [CrossRef]
- Wu, M.C.; Hou, C.Y.; Jiang, C.M.; Wang, Y.T.; Wang, C.Y.; Chen, H.H.; Chang, H.M. A novel approach of LED light radiation improves the antioxidant activity of pea seedlings. Food Chem. 2007, 101, 1753–1758. [Google Scholar] [CrossRef]
- Hasan, M.M.; Cha, M.; Bajpai, V.K.; Baek, K.H. Production of a major stilbene phytoalexin, resveratrol in peanut (Arachis hypogaea) and peanut products: A mini review. Rev. Environ. Sci. Bio/Technol. 2013, 12, 209–221. [Google Scholar] [CrossRef]
- Lopes, R.M.; Agostini-Costa, T.d.S.; Gimenes, M.A.; Silveira, D. Chemical composition and biological activities of Arachis species. J. Agric. Food Chem. 2011, 59, 4321–4330. [Google Scholar] [CrossRef] [PubMed]
- Sebei, K.; Gnouma, A.; Herchi, W.; Sakouhi, F.; Boukhchina, S. Lipids, proteins, phenolic composition, antioxidant and antibacterial activities of seeds of peanuts (Arachis hypogaea L.) cultivated in Tunisia. Biol. Res. 2013, 46, 257–263. [Google Scholar] [CrossRef] [Green Version]
- Ignatowicz, E.; Baer-Dubowska, W. Resveratrol, a natural chemopreventive agent against degenerative diseases. Pol. J. Pharmacol. 2001, 53, 557–569. [Google Scholar] [PubMed]
- Jang, M.; Cai, L.; Udeani, G.O.; Slowing, K.V.; Thomas, C.F.; Beecher, C.W.; Fong, H.H.; Farnsworth, N.R.; Kinghorn, A.D.; Mehta, R.G.; et al. Cancer chemopreventive activity of resveratrol, a natural product derived from grapes. Science 1997, 275, 218–220. [Google Scholar] [CrossRef] [Green Version]
- Cal, C.; Garban, H.; Jazirehi, A.; Yeh, C.; Mizutani, Y.; Bonavida, B. Resveratrol and cancer: Chemoprevention, apoptosis, and chemo-immunosensitizing activities. Curr. Med. Chem. Anti-Cancer Agents 2003, 3, 77–93. [Google Scholar] [CrossRef] [Green Version]
- Zhuang, H.; Kim, Y.S.; Koehler, R.C.; Dore, S. Potential mechanism by which resveratrol, a red wine constituent, protects neurons. Ann. N. Y. Acad. Sci. 2003, 993, 276–286. [Google Scholar] [CrossRef]
- Ingham, J.L. 3,5,4-Trihydroxystilbene as a phytoalexin from ground nuts (A. hypogaea). Phytochemistry 1976, 15, 1791–1793. [Google Scholar] [CrossRef]
- Hart, J.H. Role of phytostilbenes in decay and disease resistance. Annu. Rev. Phytopathol. 1981, 19, 437–458. [Google Scholar] [CrossRef]
- Jeandet, P.; Douillet-Breuil, A.C.; Bessis, R.; Debord, S.; Sbaghi, M.; Adrian, M. Phytoalexins from the Vitaceae: Biosynthesis, phytoalexin gene expression in transgenic plants, antifungal activity, and metabolism. J. Agric. Food Chem. 2002, 50, 2731–2741. [Google Scholar] [CrossRef] [PubMed]
- Cadenas, S.; Barja, G. Resveratrol, melatonin, vitamin E and PBN protect against oxidative DNA damage induced by the kidney carcinogen KBrO2, Free rad. Biol. Med. 1999, 26, 1531–1537. [Google Scholar]
- Frement, L. Biological effects of resveratrol. Life Sci. 2000, 66, 663–673. [Google Scholar] [CrossRef]
- Liu, H.K.; Cao, Y.; Huang, W.N.; Guo, Y.D.; Kang, Y.F. Effect of ethylene on total phenolics, antioxidant activity, and the activity of metabolic enzymes in mung bean sprouts. Eur. Food Res. Technol. 2013, 237, 755–764. [Google Scholar] [CrossRef]
- Swieca, M.; Gawlik-Dziki, U. Effects of sprouting and postharvest storage under cool temperature conditions on starch content and antioxidant capacity of green pea, lentil and young mung bean sprouts. Food Chem. 2015, 185, 99–105. [Google Scholar] [CrossRef]
- Li, Y.C.; Qian, H.; Sun, X.L.; Cui, Y.; Wang, H.Y.; Du, C.; Xia, X.H. The effects of germination on chemical composition of peanut seed. Food Sci. Technol. Res. 2014, 20, 883–889. [Google Scholar] [CrossRef] [Green Version]
- Limmongkon, A.; Janhom, P.; Amthong, A.; Kawpanuk, M.; Nopprang, P.; Poohadsuan, J.; Somboon, T.; Saijeen, S.; Surangkul, D.; Srikummool, M.; et al. Antioxidant activity, total phenolic, and resveratrol content in five cultivars of peanut Sprouts. Asian Pac. J. Trop. Biomed. 2017, 7, 332–338. [Google Scholar] [CrossRef]
- Chung, I.M.; Park, M.R.; Chun, J.C.; Yun, S.J. Resveratrol accumulation and resveratrol synthase gene expression in response to abiotic stresses and hormones in peanut plants. Plant Sci. 2003, 164, 103–109. [Google Scholar] [CrossRef]
- Martínez-M´arquez, A.; Morante-Carriel, J.A.; Ramírez-Estrada, K.; Cusid´o, R.M.; Palazon, J.; Bru-Martínez, R. Production of highly bioactive resveratrol analogues pterostilbene and piceatannol in metabolically engineered grapevine cell cultures. Plant Biotechnol. J. 2016, 14, 1813–1825. [Google Scholar] [CrossRef] [PubMed] [Green Version]
- Carbo, N.; Costelli, P.; Baccino, F.M.; Lopez-Soriano, F.J.; Argiles, J.M. Resveratrol, a natural product present in wine decreases tumour growth in a rat tumour model. Biochem. Biophys. Res. Commun. 1999, 254, 739–743. [Google Scholar] [CrossRef]
- Huang, C.; Ma, W.Y.; Goranson, A.; Dong, Z. Resveratrol suppresses cell transformation and induces apoptosis through a p53-dependent pathway. Carcinogenesis 1999, 20, 237–242. [Google Scholar] [CrossRef] [Green Version]
- Chang, C.C.; Lin, K.Y.; Peng, K.Y.; Day, Y.J.; Hung, L.M. Resveratrol exerts anti-obesity effects in high-fat diet obese mice and displays differential dosage effects on cytotoxicity, differentiation, and lipolysis in 3T3-L1 cells. Endocr. J. 2016, 63, 169–178. [Google Scholar] [CrossRef] [Green Version]
- Kimura, Y.; Okuda, H. Resveratrol isolated from Polygonum cuspidatum root prevents tumour growth and metastasis to lung and tumor-induced neovascularization in Lewis lung carcinoma-bearing mice. J. Nutr. 2001, 131, 1844–1849. [Google Scholar] [CrossRef]
- Wolters, D.A.; Washburn, M.P.; Yates, J.R. An automated multidimensional protein identification technology for shotgun proteomics. Anal. Chem. 2001, 73, 5683–5690. [Google Scholar]
- Liu, H.K.; Chen, Y.Y.; Hu, T.T.; Zhang, S.J.; Zhang, Y.H.; Zhao, T.Y.; Yu, H.E.; Kang, Y.F. The influence of light-emitting diodes on the phenolic compounds and antioxidant activities in pea sprouts. J. Funct. Foods 2016, 25, 459–465. [Google Scholar] [CrossRef]
- Ahn, S.Y.; Kim, S.A.; Yun, H.K. Inhibition of Botrytis cinerea and accumulation of stilbene compounds by light emitting diodes of grapevine leaves and differential expression of defense-related genes. Eur. J. Plant Pathol./Eur. Found. Plant Pathol. 2015, 143, 753–765. [Google Scholar] [CrossRef]
- Son, K.H.; Oh, M.M. Leaf Shape, Growth, and Antioxidant Phenolic Compounds of Two Lettuce Cultivars Grown under Various Combinations of Blue and Red Light-emitting Diodes. Hortiscience 2013, 48, 988–995. [Google Scholar] [CrossRef]
- Thwe, A.A.; Kim, Y.B.; Li, X.; Seo, J.M.; Kim, S.J.; Suzuki, T.; Chung, S.O.; Park, S.U. Effects of light-emitting diodes on expression of phenylpropanoid biosynthetic genes and accumulation of phenylpropanoids in Fagopyrum tataricum sprouts. J. Agric. Food Chem. 2014, 62, 4839–4845. [Google Scholar] [CrossRef] [PubMed]
- Hernández, R.; Kubota, C. Growth and morphological response of cucumber seedlings to supplemental red and blue photon flux ratios under varied solar daily light integrals. Sci. Hortic. 2014, 173, 92–99. [Google Scholar] [CrossRef]
- Hernández, R.; Kubota, C. Physiological responses of cucumber seedlings under different blue and red photon flux ratios using LEDs. Environ. Exp. Bot. 2016, 121, 66–74. [Google Scholar] [CrossRef]
- Solano, C.J.; Hernández, J.A.; Suardíaz, J.; Barba-Espín, G. Impacts of LEDs in the Red Spectrum on the Germination, Early Seedling Growth and Antioxidant Metabolism of Pea (Pisum sativum L.) and Melon (Cucumis melo L.). Agriculture 2020, 10, 204. [Google Scholar] [CrossRef]
- Zakir, H.M. Light emitting diodes increase phenolics of buckwheat (Fagopyrum esculentum) sprouts. J. Plant Interact. 2007, 2, 7178. [Google Scholar]
- Choi, H.; Moon, B.; Kang, N. Effects of LED light on the production of strawberry during cultivation in a plastic greenhouse and in a growth chamber. Sci. Hortic. 2015, 189, 22–31. [Google Scholar] [CrossRef]
- Peng, L.; Zou, L.; Su, Y.; Fan, Y.; Zhao, G. Effects of light on growth, levels of anthocyanin, concentration of metabolites in Fagopyrum tataricum sprout cultures. Int. J. Food Sci. Technol. 2015, 50, 1382–1389. [Google Scholar] [CrossRef]
- Park, C.H.; Kim, N.S.; Park, J.S.; Lee, S.Y.; Lee, J.W.; Park, S.U. Effects of light-emitting diodes on the accumulation of glucosinolates and phenolic compounds in sprouting canola (Brassica napus L.). Foods 2019, 8, 76. [Google Scholar] [CrossRef] [Green Version]
- Koga, R.; Meng, T.; Nakamura, E.; Miura, C.; Irino, N.; Devkota, H.P.; Yahara, S.; Kondo, R. The effect of photo-irradiation on the growth and ingredient composition of young green barley (Hordeum vulgare). Agric. Sci. 2013, 4, 185–194. [Google Scholar]
- Samuolienė, G.; Viršilė, A.; Brazaitytė, A.; Jankauskienė, J.; Sakalauskienė, S.; Vaštakaitė, V.; Novičkovas, A.; Viškelienė, A.; Sasnauskas, A.; Duchovskis, P. Blue light dosage affects carotenoids and tocopherols in microgreens. Food Chem. 2017, 228, 50–56. [Google Scholar] [CrossRef] [PubMed]
- Seo, J.M.; Arasu, M.V.; Kim, Y.B.; Park, S.U.; Kim, S.J. Phenylalanine and LED lights enhance phenolic compound production in tartary buckwheat sprouts. Food Chem. 2015, 177, 204–213. [Google Scholar] [CrossRef] [PubMed]
- Lee, S.W.; Seo, J.M.; Lee, M.K.; Chun, J.H.; Antonisamy, P.; Arasu, M.V.; Suzuki, T.; Al-Dhabi, N.A.; Kim, S.J. Influence of different LED lamps on the production of phenolic compounds in common and Tartary buckwheat sprouts. Ind. Crops Prod. 2014, 54, 320–326. [Google Scholar] [CrossRef]
- Ghimire, B.K.; Sacks, E.J.; Kim, S.H.; Yu, C.Y.; Chung, I.M. Profiling of phenolic compounds composition, morphological traits, and antioxidant activity of Miscanthus sacchariflorus L. accessions. Agronomy 2021, 11, 243. [Google Scholar] [CrossRef]
- Lee, M.J.; Son, J.E.; Oh, M.M. Growth and phenolic compounds of Lactuca sativa L. grown in a closed-type plant production system with UV-A, -B, or -C lamp. J. Sci. Food Agric. 2014, 942, 197–204. [Google Scholar] [CrossRef] [PubMed]
- Samuoliene, G.; Brazaityte, A.; Vaštakaite, V. Light-Emitting Diodes (LEDs) for Improved Nutritional Quality. In Light Emitting Diodes for Agriculture, 1st ed.; Dutta Gupta, S., Ed.; Springer: Singapore, 2018; pp. 149–190. [Google Scholar]
- Khattak, A.B.; Zeb, A.; Bibi, N. Impact of germination time and type of illumination on caroteinoid content, protein solubility and in-vitro protein digestibility of chickpea (Cicer arietinum L) sprouts. Food Chem. 2008, 109, 797–801. [Google Scholar] [CrossRef]
- Luczkiewicz, M.; Zarate, R.; Dembińska-Migas, W.; Migas, P.; Verpoorte, R. Production of pulchelin E in hairy roots, callus and suspension cultures of Rudbeckia hirta L. Plant Sci. 2002, 163, 91–100. [Google Scholar] [CrossRef]
- Kurutas, E.B. The importance of antioxidants which play the role in cellular response against oxidative/nitrosative stress: Current state. Nutr. J. 2016, 15, 1–22. [Google Scholar] [CrossRef] [Green Version]
- Chung, I.M.; Chelliah, R.; Oh, D.H.; Kim, S.H.; Yu, C.Y.; Ghimire, B.K. Tupistra nutans Wall. root extract, rich in phenolics, inhibits microbial growth and α-glucosidase activity, while demonstrating strong antioxidant potential. Braz. J. Bot. 2019, 42, 383–397. [Google Scholar] [CrossRef]
- Nieva Moreno, M.I.; Isla, M.I.; Sampietro, A.R.; Vattuone, M.A. Comparison of the free radicalscavenging activity of propolis from several regions of Argentina. J. Ethnopharmacol. 2000, 71, 109–114. [Google Scholar] [CrossRef]
- Chung, I.M.; Paudel, N.; Kim, S.H.; Yu, C.Y.; Ghimire, B.K. The influence of light wavelength on growth and antioxidant capacity in Pachyrhizus erosus (L.) Urban. J. Plant Growth Regul. 2019, 39, 296–312. [Google Scholar] [CrossRef]
- Thaipong, K.; Boonprakob, U.; Crosby, K.; Cisneros-Zevallos, L.; Byrne, D.H. Comparison of ABTS, DPPH, FRAP, and ORAC assays for estimating antioxidantactivity from guava fruit extracts. J. Food Compos. Anal. 2006, 19, 669–675. [Google Scholar] [CrossRef]
- Kubo, I.; Kinst-Hori, I. Tyrosinase inhibitors from anise oil. J. Agric. Food Chem. 1998, 46, 1268–1271. [Google Scholar] [CrossRef]
- Langcake, P.; Pryce, R. The production of resveratrol and the viniferins by grapevines in response to ultraviolet irradiation. Phytochem. 1977, 16, 1193–1196. [Google Scholar] [CrossRef]
- Mosmann, T. Rapid colorimetric assay for cellular growth and survival: Application to proliferation and cytotoxicity assays. J. Immunol. Methods 1983, 65, 55–63. [Google Scholar] [CrossRef]
- Bian, Z.H.; Yang, Q.C.; Liu, W.K. Effects of light quality on the accumulation of phytochemicals in vegetables produced in controlled environments: A review. J. Sci. Food Agric. 2015, 95, 869–877. [Google Scholar] [CrossRef] [PubMed]
- Demotes-Mainard, S.; Péron, T.; Corot, A.; Bertheloot, J.; Le Gourrierec, J.; Pelleschi-Travier, S.; Crespel, L.; Morel, P.; Huché-Thélier, L.; Boumaza, R.; et al. Plant responses to red and far-red lights, applications in horticulture. Environ. Exp. Bot. 2016, 121, 4–21. [Google Scholar] [CrossRef]
- Huché-Thélier, L.; Crespel, L.; Le Gourrierec, J.; Morel, P.; Sakr, S.; Leduc, N. Light signaling and plant responses to blue and UV radiations-perspectives for applications in horticulture. Environ. Exp. Bot. 2016, 121, 22–38. [Google Scholar] [CrossRef]
- Cuong, D.M.; Ha, T.W.; Park, C.H.; Kim, N.S.; Yeo, H.J.; Chun, S.W.; Kim, C.; Park, S.U. Effects of LED lights on Expression of Genes Involved in Phenylpropanoid Biosynthesis and Accumulation of Phenylpropanoids in Wheat Sprout. Agronomy 2019, 9, 307. [Google Scholar] [CrossRef] [Green Version]
- Lian, T.T.; Cha, S.Y.; Moe, M.M.; Kim, Y.J.; Bang, K.S. Effects of different colored LEDs on the enhancement of biologically active ingredients in callus cultures of Gynura procumbens (Lour.) Merr. Molecules 2019, 24, 4336. [Google Scholar] [CrossRef] [PubMed] [Green Version]
- Del Valle, J.C.; Buide, M.L.; Whittall, J.B.; Valladares, F.; Narbona, E. UV radiation increases phenolic compound protection but decreases reproduction in Silene littorea. PLoS ONE 2020, 15, e0231611. [Google Scholar] [CrossRef]
- Ebisawa, M.; Shoji, K.; Kato, M.; Shimomura, K.; Goto, F.; Yoshihara, T. Supplementary ultraviolet radiation B together with blue light at night increased qercetin content and flavonol systhase gene expression in leaf lettuce (Lactuca sativa L.). Environ. Control Biol. 2008, 46, 1–11. [Google Scholar] [CrossRef] [Green Version]
- Ryan, K.G.; Swinny, E.E.; Markham, K.R.; Winefield, C. Flavonoid gene expression and UV photoprotection in transgenic and mutant Petunia leaves. Phytochemistry 2002, 59, 23–32. [Google Scholar] [CrossRef]
- Amoozgar, A.; Mohammadi, A.; Sabzalian, M.R. Impact of light-emitting diode irradiation on photosynthesis, phytochemical composition and mineral element content of lettuce cv. Grizzly. Photosynthetica 2017, 55, 85–95. [Google Scholar] [CrossRef]
- Guo, J.; Wang, M.H. Ultraviolet A-specific induction of anthocyanin biosynthesis and PAL expression in tomato (Solanum lycopersicum L.). Plant Growth Regul. 2010, 621, 1–8. [Google Scholar] [CrossRef]
- Kopeć, A.; Piątkowska, E.; Leszczyńska, T.; Bieżanowska-Kopeć, R. Health-promoting affects of resveratrol. ŻYWNOŚĆ. Nauka. Technol. Jakość. 2011, 5, 5–15. (In Polish) [Google Scholar]
- Cordova-Gomez, M.; Galano, A.; Raul, J.; Alvarez-Idaboy, J.R. Piceatannol, a better peroxyl radical scavenger than resveratrol. RSC Adv. 2013, 3, 20209–20218. [Google Scholar] [CrossRef]
- Robb, E.L.; Page, M.M.; Wiens, B.E.; Stuart, J.A. Molecular mechanisms of oxidative stress resistance induced by resveratrol: Specific and progressive induction of MnSOD. Biochem. Biophys. Res. Commun. 2008, 367, 406–412. [Google Scholar] [CrossRef] [PubMed]
- Kavas, G.O.; Ayral, P.A.; Elhan, A.H. The Effects of Resveratrol on Oxidant/Antioxidant Systems and Their Cofactors in Rats. Adv. Clin. Exp. Med. 2013, 22, 151–155. [Google Scholar]
- Figueiras, T.S.; Neves-Petersen, M.T.; Petersen, S.B. Activation Energy of Light Induced Isomerization of Resveratrol. J. Fluoresc. 2011, 21, 1897–1906. [Google Scholar] [CrossRef] [PubMed]
- Zheng, L.; Van Labeke, M.C. Chrysanthemum morphology, photosynthetic efficiency and antioxidant capacity are differentially modified by light quality. J. Plant Physiol. 2017, 213, 66–74. [Google Scholar] [CrossRef]
- Li, Q.; Kubota, C. Effects of supplemental light quality on growth and phytochemicals of baby leaf lettuce. Environ. Exp. Bot. 2009, 67, 59–64. [Google Scholar] [CrossRef]
- Shahidi, F.; Ambigaipalan, P. Phenolics and polyphenolics in foods, beverages and spices: Antioxidant activity and health effects—A review J. Funct. Foods 2015, 18, 820–897. [Google Scholar] [CrossRef]
- Leonard, S.; Xia, C.; Jiang, B.H.; Stinefelt, B.; Klandorf, H.; Harris, G.K.; Shi, X. Resveratrol scavenges reactive oxygen species and effects radical-induced cellular responses. Biochem. Biophys. Res. Commun. 2003, 309, 1017–1026. [Google Scholar] [CrossRef]
- Losa, G.A. Resveratrol modulates apoptosis and oxidation in human blood mononuclear cells. Eur. J. Clin. Investig. 2003, 33, 818–823. [Google Scholar] [CrossRef] [PubMed]
- Martinez, J.; Moreno, J.J. Effect of resveratrol, a natural polyphenolic compound, on reactive oxygen species and prostaglandin production. Biochem. Pharm. 2000, 59, 865–870. [Google Scholar] [CrossRef]
- Zini, R.; Morin, C.; Bertelli, A.; Tillement, J.P. Effects of resveratrol on the rat brain respiratory chain. Drugs Experimen. Clin. Res. 1999, 25, 87. [Google Scholar]
- Yen, G.C.; Duh, P.D.; Lin, C.W. Effects of Resveratrol and 4-hexylresorcinol on Hydrogen Peroxide-induced Oxidative DNA Damage in Human Lymphocytes. Free Radic. Res. 2003, 37, 509–514. [Google Scholar] [CrossRef] [PubMed]
- Ma, Y.; Kosinska-Cagnazzo, A.; Kerr, W.L.; Amarowicz, R.; Swanson, R.B.; Pegg, R.B. Separation and characterization of phenolic compounds from dry-blanched peanut skins by liquid chromatography-electrospray ionization mass spectrometry. J. Chromatogr. A 2014, 1356, 64–81. [Google Scholar] [CrossRef]
- Francisco, M.L.D.; Resurreccion, A.V.A. Development of a reversed-phase high performance liquid chromatography (RPHPLC) procedure for the simultaneous determination of phenolic compounds in peanut skin extracts. Food Chem. 2009, 117, 356–363. [Google Scholar] [CrossRef]
- Attree, R.; Du, B.; Xu, B. Distribution of phenolic compounds in seed coat and cotyledon, and their contribution to antioxidant capacities of red and black seed coat peanuts (Arachis hypogaea L.). Ind. Crop. Prod. 2015, 67, 448–456. [Google Scholar] [CrossRef]
- Abdillahi, H.S.; Verschaeve, L.; Finnie, J.F.; Van Staden, J. Mutagenicity, antimutagenicity and cytotoxicity evaluation of South African Podocarpus species. J. Ethnopharmacol. 2012, 139, 728–738. [Google Scholar] [CrossRef]
- González-Sarrías, A.; Núñez-Sánchez, M.Á.; Tomás-Barberán, F.A.; Espín, J.C. Neuroprotective effects of bioavailable polyphenol-derived metabolites against oxidative stress-induced cytotoxicity in human neuroblastoma SH-SY5Y cells. J. Agric. Food Chem. 2017, 65, 752–758. [Google Scholar] [CrossRef] [Green Version]
- Smeriglio, A.; Cornara, L.; Denaro, M.; Barreca, D.; Burlando, B.; Xiao, J.; Trombetta, D. Antioxidant and cytoprotective activities of an ancient Mediterranean citrus (Citrus lumia Risso) albedo extract: Microscopic observations and polyphenol characterization. Food Chem. 2019, 279, 347–355. [Google Scholar] [CrossRef] [PubMed]
- Matsuo, M.; Sasaki, N.; Saga, K.; Kaneko, T. Cytotoxicity of Flavonoids toward Cultured Normal Human Cells. Biol. Pharm. Bull. 2005, 28, 253–259. [Google Scholar] [CrossRef] [PubMed] [Green Version]
- Mahady, G.B.; Pendland, S.L. Resveratrol inhibits the growth of Helicobacter pylori in vitro. Am. J. Gastroenterol. 2000, 95, 1849. [Google Scholar] [CrossRef]
- Docherty, J.J.; Fu, M.M.; Tsai, M. Resveratrol selectively inhibits Neisseria gonorrhoeae and Neisseria meningitidis. J. Antimicrob. Chemother. 2001, 47, 243–244. [Google Scholar] [CrossRef] [Green Version]
- Chan, M.M.Y. Antimicrobial effect of resveratrol on dermatophytes and bacterial pathogens of the skin. Biochem. Pharmacol. 2002, 63, 99–104. [Google Scholar] [CrossRef]
- Tegos, G.; Stermitz, F.R.; Lomovskaya, O.; Lewis, K. Multidrug pump inhibitors uncover remarkable activity of plant antimicrobials. Antimicrob. Agents Chemother. 2002, 46, 3133–3141. [Google Scholar] [CrossRef] [PubMed] [Green Version]
- Paulo, L.; Ferreira, S.; Gallardo, E.; Queiroz, J.A.; Domingues, F. Antimicrobial activity and effects of resveratrol on human pathogenic bacteria. World J. Microbiol. Biotechnol. 2010, 26, 1533–1538. [Google Scholar] [CrossRef]
- Emma, J.M.T.; Yang, Y.; Champer, J.; Kim, J. Resveratrol Demonstrates Antimicrobial Effects against Propionibacterium acnes In Vitro. Dermatol. Ther. 2014, 4, 249–257. [Google Scholar]
- Lechner, D.; Gibbons, S.; Bucar, F. Plant phenolic compounds as ethidium bromide efflux inhibitors in Mycobacterium smegmatis. J. Antimicrob. Chemother. 2008, 62, 345–348. [Google Scholar] [CrossRef] [Green Version]
- Augustine, N.; Goel, A.; Sivakumar, K.; Kumar, R.A.; Thomas, S. Resveratrol—A potential inhibitor of biofilm formation in Vibrio cholerae. Phytomedicine 2014, 21, 286–289. [Google Scholar] [CrossRef] [PubMed]
- Duarte, A.; Alves, A.C.; Ferreira, S.; Silva, F.; Domingues, F.C. Resveratrol inclusion complexes: Antibacterial and anti-biofilm activity against Campylobacter spp. and Arcobacter butzleri. Food Res. Int. 2015, 77, 244–250. [Google Scholar] [CrossRef]
- Sun, D.; Hurdle, J.G.; Lee, R.; Lee, R.; Cushman, M.; Pezzuto, J.M. Evaluation of flavonoid and resveratrol chemical libraries reveals abyssinone II as a promising antibacterial lead. ChemMedChem 2012, 7, 1541–1545. [Google Scholar] [CrossRef] [Green Version]
- Ferreira, S.; Silva, F.; Queiroz, J.A.; Oleastro, M.; Domingues, F.C. Resveratrol against Arcobacter butzleri and Arcobacter cryaerophilus: Activity and effect on cellular functions. Int. J. Food Microbiol. 2014, 180, 62–68. [Google Scholar] [CrossRef]
- Dadi, P.K.; Ahmad, M.; Ahmad, Z. Inhibition of ATPase activity of Escherichia coli ATP synthase by polyphenols. Int. J. Biol. Macromol. 2009, 45, 72–79. [Google Scholar] [CrossRef] [PubMed]
- Hwang, D.; Lim, Y.H. Resveratrol antibacterial activity against Escherichia coli is mediated by Z-ring formation inhibition via suppression of FtsZ expression. Sci. Rep. 2015, 5, 10029. [Google Scholar] [CrossRef] [PubMed]
- Subramanian, M.; Goswami, M.; Chakraborty, S.; Jawali, N. Resveratrol induced inhibition of Escherichia coli proceeds via membrane oxidation and independent of diffusible reactive oxygen species generation. Redox Biol. 2014, 2, 865–872. [Google Scholar] [CrossRef] [PubMed] [Green Version]
- Docherty, J.J.; McEwen, H.A.; Sweet, T.J.; Bailey, E.; Booth, T.D. Resveratrol inhibition of Propionibacterium acnes. J. Antimicrob. Chemother. 2007, 59, 1182–1184. [Google Scholar] [CrossRef] [PubMed] [Green Version]
- Jung, H.J.; Hwang, I.A.; Sung, W.S.; Kang, H.; Kang, B.S.; Seu, Y.B.; Lee, D.G. Fungicidal effect of resveratrol on human infectious fungi. Arch. Pharm. Res. 2005, 28, 557–560. [Google Scholar] [CrossRef]
- Kato, E.; Tokunaga, Y.; Sakan, F. Stilbenoids isolated from the seeds of Melinjo (Gnetum gnemon L.) and their biological activity. J. Agric. Food Chem. 2009, 57, 2544–2549. [Google Scholar] [CrossRef]
- Pettit, G.R.; Grealish, M.P.; Jung, M.K.; Hamel, E.; Pettit, R.K.; Chapuis, J.C.; Schmidt, J.M. Antineoplastic agents. 465. Structural modification of resveratrol: Sodium resverastatin phosphate. J. Med. Chem. 2002, 45, 2534–2542. [Google Scholar] [CrossRef]
- Coenye, T.; Brackman, G.; Rigole, P.; De Witte, E.; Honraet, K.; Rossel, B.; Nelis, H.J. Eradication of Propionibacterium acnes biofilms by plant extracts and putative identification of icariin, resveratrol and salidroside as active compounds. Phytomedicine 2012, 19, 409–412. [Google Scholar] [CrossRef] [PubMed]
- Lee, S.W.; Seo, J.M.; Lee, M.K.; Chun, J.H.; Antonisamy, P.; Arasu, M.V.; Suzuki, T.; Al Dhabi, N.A.; Lee, J.H.; Cho, H.S.; et al. Diverse plant extracts and trans-resveratrol inhibit biofilm formation and swarming of Escherichia coli O157: H7. Biofouling 2013, 29, 1189–1203. [Google Scholar] [CrossRef] [PubMed]
- Jenkins, G.I. UV-A and blue light signal transduction in Arabidopsis. Plant Cell Environ. 1997, 20, 773–778. [Google Scholar] [CrossRef] [PubMed] [Green Version]

| Light | Resveratrol (μg g−1) |
|---|---|
| FL | 0.360 ± 0.020 c |
| RL | 0.160 ± 0.009 a |
| BL | 0.395 ± 0.010 d |
| GL | 0.390 ± 0.020 d |
| MEL | 0.200 ± 0.010 b |
| UL | <LOQ 1 |
| Microbial Strains | UL | FL | RL | BL | GL | MEL |
|---|---|---|---|---|---|---|
| -------------------------------------Zone of Inhibition (mm)----------------------------- | ||||||
| Vibrio litoralis (KCTC12320) | 3.34 ± 0.50 b | 5.50 ± 0.80 c | 2.50 ± 0.50 a | 8.35 ± 0.60 c | 3.56 ± 0.40 a | 5.15 ± 0.90 c |
| Klebsiella pneumoniae (ATCC 9621) | 6.00 ± 2.16 d | 6.11 ± 1.63 d | 6.50 ± 2.45 b | 7.67 ± 2.05 b | 5.67 ± 2.00 c | 5.00 ± 1.63 c |
| Bacillus subtilis (KCCM 11316) | ND | ND | ND | ND | ND | ND |
| Escherichia coli (ATCC35150) | 2.00 ± 0.30 a | 5.10 ± 0.80 c | 6.20 ± 0.70 b | 9.50 ± 1.50 d | 4.50 ± 0.90 b | 2.10 ± 0.50 b |
| Salmonella enteritidis (ATCC14028) | 3.20 ± 0.30 b | 1.10 ± 0.20 a | 2.30 ± 0.50 a | 8.50 ± 0.20 c | 8.00 ± 0.50 d | 1.00 ± 0.10 a |
| Pseudomonas aeruginosa (ATCC25668) | 5.67 ± 1.89 c | 4.50 ± 1.63 b | 8.00 ± 2.45 c | 5.00 ± 0.81 a | 4.67 ± 1.69 b | 2.00 ± 0.81 b |
Publisher’s Note: MDPI stays neutral with regard to jurisdictional claims in published maps and institutional affiliations. |
© 2021 by the authors. Licensee MDPI, Basel, Switzerland. This article is an open access article distributed under the terms and conditions of the Creative Commons Attribution (CC BY) license (http://creativecommons.org/licenses/by/4.0/).
Share and Cite
Chung, I.-M.; Lee, C.; Hwang, M.H.; Kim, S.-H.; Chi, H.-Y.; Yu, C.Y.; Chelliah, R.; Oh, D.-H.; Ghimire, B.K. The Influence of Light Wavelength on Resveratrol Content and Antioxidant Capacity in Arachis hypogaeas L. Agronomy 2021, 11, 305. https://doi.org/10.3390/agronomy11020305
Chung I-M, Lee C, Hwang MH, Kim S-H, Chi H-Y, Yu CY, Chelliah R, Oh D-H, Ghimire BK. The Influence of Light Wavelength on Resveratrol Content and Antioxidant Capacity in Arachis hypogaeas L. Agronomy. 2021; 11(2):305. https://doi.org/10.3390/agronomy11020305
Chicago/Turabian StyleChung, Ill-Min, Changhwan Lee, Myeong Ha Hwang, Seung-Hyun Kim, Hee-Yeon Chi, Chang Yeon Yu, Ramachandran Chelliah, Deog-Hwan Oh, and Bimal Kumar Ghimire. 2021. "The Influence of Light Wavelength on Resveratrol Content and Antioxidant Capacity in Arachis hypogaeas L." Agronomy 11, no. 2: 305. https://doi.org/10.3390/agronomy11020305






